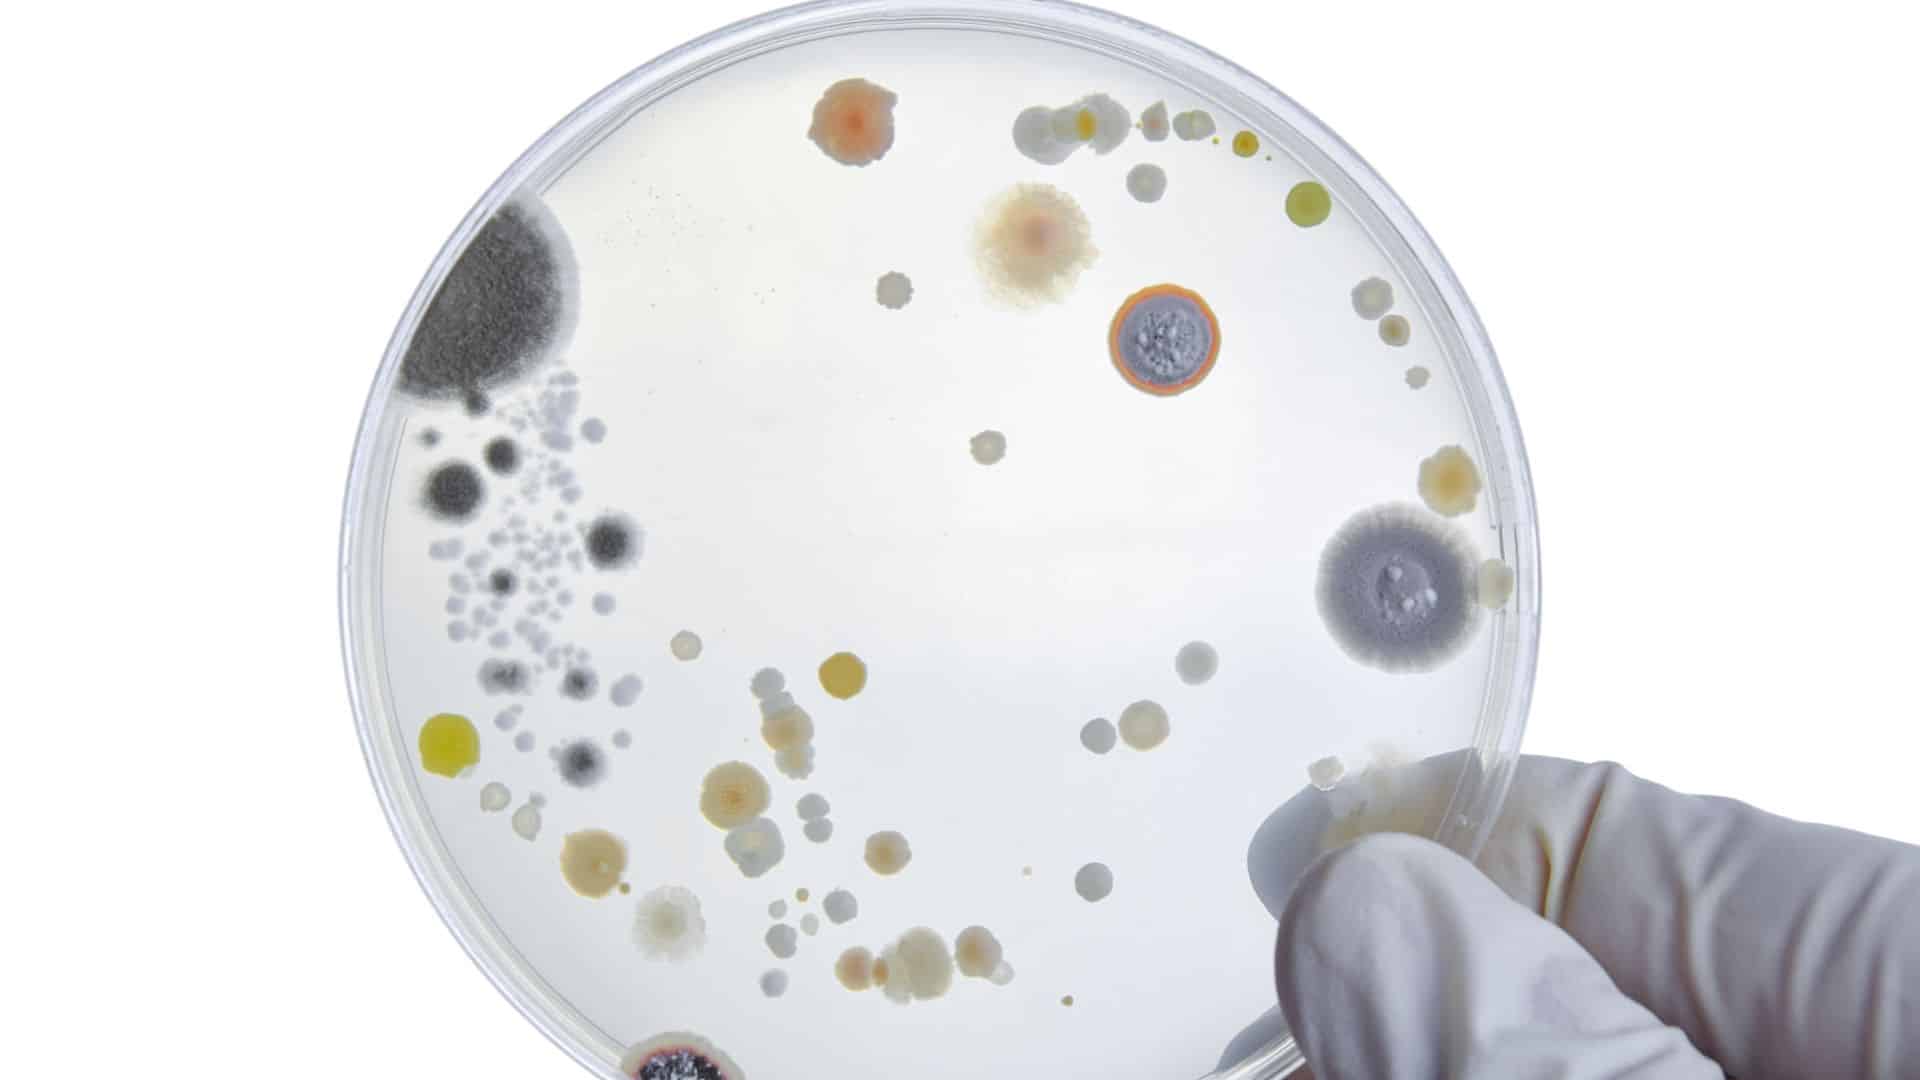
Bacteria cultures on petri dish

TikTok Reveals British Dish-Washing Trick That Skips Rinsing, Experts Explain


A viral TikTok by user @spiritual_af has exposed a cultural divide in dishwashing techniques between Americans and the British. The method, known as “washing up,” involves scrubbing dishes with a sponge in soapy water before placing them directly on the drying rack with suds still clinging to the surface. No rinsing step occurs, and the soap simply drips off as the dishes air dry. Viewers flooded the comments with bewilderment, questioning whether leaving soap residue on dishes could be safe or hygienic.
The New York Times reported on the debate by questioning two London-based friends about the practice. The native Brit replied, “I don’t know anyone who doesn’t wash the suds off,” suggesting the practice may not be universal. However, the American expat living in London offered a different perspective, saying, “I’ve had more experiences of tasting dish soapy flavors in food than ever before here,” indicating the no-rinse method does exist among some British households despite not being universally adopted.
Defenders of the method point to water conservation, with one TikTok commenter writing, “Americans are unaware of the concept of saving water.” The technique also eliminates a step in the dishwashing process, saving time with each session. However, health and cleaning experts offer conflicting perspectives on whether this shortcut compromises dish hygiene. While some note that dish soap carries relatively low toxicity, others warn about bacterial growth on improperly cleaned dishes and the potential for illness from contaminated surfaces.
Soap Residue Doesn’t Fully Drip Away As Expected

Toby Schulz, CEO and co-founder of Maid2Match, explains that the no-rinse method relies on water carrying soap molecules and dirt away as it flows off in the drying rack. However, this doesn’t always work in practice. “Not all the water will run off—some of it will evaporate or dry on the dishes instead,” he says. Dish soap works through surfactants, which are molecules designed to bind to both water and grease. Without rinsing them off, those surfactants remain on your dishes.
Dr. Maryann Amirshahi, co-medical director of the National Capital Poison Center, offers a perspective on the safety question. After noting that formal research on the topic remains limited, she says the practice probably is safe, “given that this practice is not new and has not been linked to adverse outcomes.” The reason comes down to exposure levels. “Dish soaps are relatively non-toxic, and the amount an individual is exposed to would be small,” Amirshahi explains, noting it’s possible long-term effects exist but remain difficult to study.
Amirshahi points out another factor that may reduce risk: how people typically handle dishes after washing. If you dry your dishes with a towel rather than letting them air dry completely, you’ll likely wipe away soap residue in the process, she notes. This mechanical action removes surfactant film that would otherwise remain on dish surfaces. However, she clarifies that while small soap exposures are relatively low risk, rinsing remains advisable to avoid any unnecessary exposure to detergent ingredients.
Skipping Rinse Creates an Environment For Bacterial Growth
Beyond soap residue, skipping the rinse step creates another concern that health experts consider more serious. Dr. Vanessa Coffman, Alliance Director at Stop Foodborne Illness, warns that food residue sticks to dishes when they’re not properly rinsed. “Soap residues, along with organic matter, can provide a moist environment that supports microbial growth,” she says. The combination of leftover food particles and lingering moisture creates conditions where bacteria can multiply on supposedly clean dishes, potentially leading to foodborne illness.
Coffman emphasizes that improper rinsing doesn’t just leave bacteria on dishes—it actively creates conditions where they can reproduce. “If you skip the rinsing step, not only are you not removing bacteria, but you’re creating a place where they may start multiplying, which can lead to illness,” she explains. This warning highlights how the no-rinse method poses health risks beyond chemical residue concerns, introducing the potential for actual bacterial contamination and the illnesses that follow.
The bacterial growth concern represents the primary health risk that experts emphasize when discussing the no-rinse method. While soap residue itself carries relatively low toxicity according to poison control experts, the failure to remove food particles through rinsing creates an environment where harmful bacteria can thrive. Coffman’s focus on microbial growth and illness risk underscores why health professionals recommend rinsing despite the seemingly benign nature of trace amounts of soap. The real danger lies in what gets left behind when dishes aren’t properly cleaned.
Health Experts Recommend Rinsing To Prevent Contamination

Dr. Kaitlyn Brown, clinical managing director for America’s Poison Centers, delivers a clear recommendation despite the relatively low toxicity of dish soap. “While dish soap residue is unlikely to cause any acute health effects, we would recommend rinsing off residual dish soap to avoid unnecessary exposure to the ingredients,” she says. Amirshahi agrees, adding that rinsing serves purposes beyond removing soap. “The mechanical act of rinsing can remove additional food particles that can harbor bacteria,” she explains, addressing the contamination risks Coffman highlighted.
Coffman recommends taking an extra step beyond basic rinsing to ensure dishes are truly hygienic. To sanitize properly, you can use a sanitizing solution or submerge dishes in very hot water at approximately 171 degrees Fahrenheit for 30 seconds. Schulz adds that dishwashers provide the most reliable cleaning method, as the water used in both wash and rinse cycles reaches temperatures hot enough to kill lingering germs. “In combination with a good detergent, that’ll get rid of most grease and grime,” he says.
Amirshahi emphasizes that proper dish care extends beyond the washing and rinsing process. Dishes must be completely dry before being put away in cabinets or on shelves. “Putting away or stacking dishes that are wet can allow for bacteria and other germs to grow on the surface,” she points out. The consensus among health experts is clear: while the British washing-up method may not cause immediate harm from soap exposure, rinsing remains essential for protecting against bacterial contamination and the illnesses it can cause.